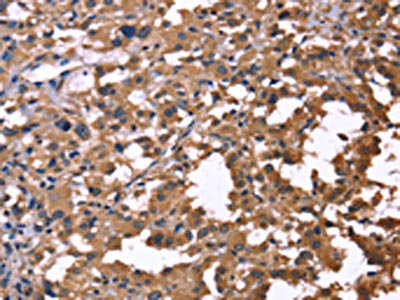
CSB-PA584603

IL1A
IL1A,即白細胞介素1α,別名IL-1α、Hematopoietin-1、Lymphocyte-Activating Factor (LAF)、Endogenous Pyrogen (EP)、IL1F1等。它是一種由IL1A基因編碼的多效性細胞因子,主要由活化的巨噬細胞、中性粒細胞、上皮細胞和內皮細胞產生 。IL1A的作用機制涉及其前體蛋白在細胞內的轉錄因子功能以及成熟形式在細胞外的信號傳導作用。IL1A前體在細胞核內促進基因表達,調控細胞生長和分化。成熟形式的IL1A通過與細胞表面的IL-1受體IL1R1結合,觸發信號傳導復合物的形成,激活NF-kappa-B和MAPK通路,從而引發炎癥反應和免疫應答 。在生物學意義上,IL1A在機體的炎癥反應、免疫調節以及與多種疾病的關聯中發揮關鍵作用。它參與機體抗微生物感染、無菌炎癥、腫瘤相關疾病以及自發炎癥的調節。IL1A的異常表達與多種疾病有關,包括Fabry病、Schnitzler綜合征、多種自身免疫性疾病、血液腫瘤和肺部疾病等。因此,IL1A是炎癥和免疫相關疾病研究中的一個重要分子靶點,并且是臨床治療多種疾病的潛在標志物和治療靶點 。
熱銷產品
Recombinant Human Interleukin-1 alpha (IL1A) (CSB-YP011613HU)
驗證數據

(Tris-Glycine gel) Discontinuous SDS-PAGE (reduced) with 5% enrichment gel and 15% separation gel.
驗證數據

The image on the left is immunohistochemistry of paraffin-embedded Human colon cancer tissue using CSB-PA584603(IL1A Antibody) at dilution 1/60, on the right is treated with fusion protein. (Original magnification: ×200)
The image on the left is immunohistochemistry of paraffin-embedded Human thyroid cancer tissue using CSB-PA584603(IL1A Antibody) at dilution 1/60, on the right is treated with fusion protein. (Original magnification: ×200)

Gel: 8%SDS-PAGE, Lysate: 40 μg, Lane: Jurkat cells, Primary antibody: CSB-PA584603(IL1A Antibody) at dilution 1/666, Secondary antibody: Goat anti rabbit IgG at 1/8000 dilution, Exposure time: 20 seconds
Human Interleukin 1α,IL-1α ELISA Kit (CSB-E04620h)
驗證數據
貨號:CSB-E04620h
規格:96T/48T
靈敏度:0.975 pg/ml.
檢測范圍:3.9 pg/ml-250 pg/ml.
These standard curves are provided for demonstration only. A standard curve should be generated for each set of samples assayed.
IL1A Antibodies
IL1A for Homo sapiens (Human)
| 產品貨號 | 產品名稱 | 種屬反應性 | 應用類型 |
|---|---|---|---|
| CSB-PA06565A0Rb | IL1A Antibody | Human | ELISA |
| CSB-PA06565C0Rb | IL1A Antibody, FITC conjugated | Human | |
| CSB-PA011613GA01HU | IL1A Antibody | Human | ELISA,WB |
| CSB-PA009537 | IL1A Antibody | Human,Mouse,Rat | IHC, ELISA |
| CSB-PA107052 | IL1A Antibody | Human | ELISA,IHC |
| CSB-PA584603 | IL1A Antibody | Human | ELISA,WB,IHC |
IL1A for Macaca mulatta
| 產品貨號 | 產品名稱 | 種屬反應性 | 應用類型 |
|---|---|---|---|
| CSB-PA011613LA01MOW | IL1A Antibody | Macaca mulatta, Human | ELISA, WB |
IL1A Proteins
IL1A Proteins for Capra hircus (Goat)
| 產品貨號 | 產品名稱 | 來源 |
|---|---|---|
| CSB-YP011613GO CSB-EP011613GO CSB-BP011613GO CSB-MP011613GO CSB-EP011613GO-B |
Recombinant Goat Interleukin-1 alpha (IL1A) | Yeast E.coli Baculovirus Mammalian cell In Vivo Biotinylation in E.coli |
IL1A Proteins for Sus scrofa (Pig)
| 產品貨號 | 產品名稱 | 來源 |
|---|---|---|
| CSB-YP011613PI CSB-EP011613PI CSB-BP011613PI CSB-MP011613PI CSB-EP011613PI-B |
Recombinant Pig Interleukin-1 alpha (IL1A) | Yeast E.coli Baculovirus Mammalian cell In Vivo Biotinylation in E.coli |
IL1A Proteins for Macaca mulatta (Rhesus macaque)
| 產品貨號 | 產品名稱 | 來源 |
|---|---|---|
| CSB-YP011613MOW | Recombinant Macaca mulatta Interleukin-1 alpha (IL1A) | Yeast |
| CSB-AP003071MOW | Recombinant Macaca mulatta Interleukin-1 alpha (IL1A) (Active) | E.Coli |
| CSB-EP011613MOW | Recombinant Macaca mulatta Interleukin-1 alpha (IL1A) | E.coli |
| CSB-BP011613MOW CSB-MP011613MOW CSB-EP011613MOW-B |
Recombinant Macaca mulatta Interleukin-1 alpha (IL1A) | Baculovirus Mammalian cell In Vivo Biotinylation in E.coli |
IL1A Proteins for Mus musculus (Mouse)
| 產品貨號 | 產品名稱 | 來源 |
|---|---|---|
| CSB-YP011613MO CSB-EP011613MO CSB-BP011613MO CSB-MP011613MO CSB-EP011613MO-B |
Recombinant Mouse Interleukin-1 alpha (Il1a) | Yeast E.coli Baculovirus Mammalian cell In Vivo Biotinylation in E.coli |
| CSB-AP003251MO | Recombinant Mouse Interleukin-1 alpha protein (Il1a) | E.Coli |
| CSB-AP004721MO | Recombinant Mouse Interleukin-1 alpha (Il1a) (Active) | E.coli |
IL1A Proteins for Homo sapiens (Human)
| 產品貨號 | 產品名稱 | 來源 |
|---|---|---|
| CSB-YP011613HU | Recombinant Human Interleukin-1 alpha (IL1A) | Yeast |
| CSB-EP011613HUe0 | Recombinant Human Interleukin-1 alpha (IL1A) | E.coli |
| CSB-EP011613HU | Recombinant Human Interleukin-1 alpha (IL1A) | E.coli |
| CSB-AP001661HU | Recombinant Human Interleukin-1 alpha protein (IL1A) | E.Coli |
| CSB-BP011613HU CSB-MP011613HU |
Recombinant Human Interleukin-1 alpha (IL1A) | Baculovirus Mammalian cell |
| CSB-YP011613HUc7 | Recombinant Human Interleukin-1 alpha (IL1A) | Yeast |
| CSB-AP004261HU | Recombinant Human Interleukin-1 alpha (IL1A) (Active) | E.coli |
| CSB-AP005801HU | Recombinant Human Interleukin-1 alpha (IL1A) (Active) (GMP) | E.Coli |
| CSB-EP011613HU-B | Recombinant Human Interleukin-1 alpha (IL1A),Biotinylated | E.coli |
IL1A Proteins for Bos taurus (Bovine)
| 產品貨號 | 產品名稱 | 來源 |
|---|---|---|
| CSB-YP011613BO CSB-BP011613BO CSB-MP011613BO CSB-EP011613BO-B |
Recombinant Bovine Interleukin-1 alpha (IL1A) | Yeast Baculovirus Mammalian cell In Vivo Biotinylation in E.coli |
IL1A Proteins for Oryctolagus cuniculus (Rabbit)
| 產品貨號 | 產品名稱 | 來源 |
|---|---|---|
| CSB-YP011613RB CSB-EP011613RB CSB-BP011613RB CSB-MP011613RB CSB-EP011613RB-B |
Recombinant Rabbit Interleukin-1 alpha (IL1A) | Yeast E.coli Baculovirus Mammalian cell In Vivo Biotinylation in E.coli |
IL1A Proteins for Felis catus (Cat) (Felis silvestris catus)
| 產品貨號 | 產品名稱 | 來源 |
|---|---|---|
| CSB-YP011613CA CSB-EP011613CA CSB-BP011613CA CSB-MP011613CA CSB-EP011613CA-B |
Recombinant Cat Interleukin-1 alpha (IL1A) | Yeast E.coli Baculovirus Mammalian cell In Vivo Biotinylation in E.coli |
IL1A Proteins for Canis familiaris (Dog) (Canis lupus familiaris)
| 產品貨號 | 產品名稱 | 來源 |
|---|---|---|
| CSB-YP011613DO CSB-EP011613DO CSB-BP011613DO CSB-MP011613DO CSB-EP011613DO-B |
Recombinant Dog Interleukin-1 alpha (IL1A) | Yeast E.coli Baculovirus Mammalian cell In Vivo Biotinylation in E.coli |
IL1A Proteins for Macaca fascicularis (Crab-eating macaque) (Cynomolgus monkey)
| 產品貨號 | 產品名稱 | 來源 |
|---|---|---|
| CSB-BP011613MOV CSB-MP011613MOV CSB-EP011613MOV-B |
Recombinant Macaca fascicularis Interleukin-1 alpha (IL1A) | Baculovirus Mammalian cell In Vivo Biotinylation in E.coli |
IL1A Proteins for Rattus norvegicus (Rat)
| 產品貨號 | 產品名稱 | 來源 |
|---|---|---|
| CSB-YP011613RA CSB-EP011613RA CSB-BP011613RA CSB-MP011613RA CSB-EP011613RA-B |
Recombinant Rat Interleukin-1 alpha (Il1a) | Yeast E.coli Baculovirus Mammalian cell In Vivo Biotinylation in E.coli |
IL1A Proteins for Cercocebus atys (Sooty mangabey) (Cercocebus torquatus atys)
| 產品貨號 | 產品名稱 | 來源 |
|---|---|---|
| CSB-YP011613DRI CSB-EP011613DRI CSB-BP011613DRI CSB-MP011613DRI CSB-EP011613DRI-B |
Recombinant Cercocebus atys Interleukin-1 alpha (IL1A) | Yeast E.coli Baculovirus Mammalian cell In Vivo Biotinylation in E.coli |
IL1A Proteins for Ovis aries (Sheep)
| 產品貨號 | 產品名稱 | 來源 |
|---|---|---|
| CSB-YP630687SH CSB-EP630687SH CSB-BP630687SH CSB-MP630687SH CSB-EP630687SH-B |
Recombinant Sheep Interleukin-1 alpha (IL1A) | Yeast E.coli Baculovirus Mammalian cell In Vivo Biotinylation in E.coli |
IL1A Proteins for Equus caballus (Horse)
| 產品貨號 | 產品名稱 | 來源 |
|---|---|---|
| CSB-YP636720HO CSB-EP636720HO CSB-BP636720HO CSB-MP636720HO CSB-EP636720HO-B |
Recombinant Horse Interleukin-1 alpha (IL1A) | Yeast E.coli Baculovirus Mammalian cell In Vivo Biotinylation in E.coli |
IL1A Proteins for Bubalus carabanensis (Swamp type water buffalo) (Bubalus bubalis carabanensis)
| 產品貨號 | 產品名稱 | 來源 |
|---|---|---|
| CSB-YP661675BAAW CSB-EP661675BAAW CSB-BP661675BAAW CSB-MP661675BAAW CSB-EP661675BAAW-B |
Recombinant Bubalus carabanensis Interleukin-1 alpha (IL1A) | Yeast E.coli Baculovirus Mammalian cell In Vivo Biotinylation in E.coli |
IL1A Proteins for Cavia porcellus (Guinea pig)
| 產品貨號 | 產品名稱 | 來源 |
|---|---|---|
| CSB-YP733672GU CSB-EP733672GU CSB-BP733672GU CSB-MP733672GU CSB-EP733672GU-B |
Recombinant Guinea pig Interleukin-1 alpha (IL1A) | Yeast E.coli Baculovirus Mammalian cell In Vivo Biotinylation in E.coli |
IL1A Proteins for Lama glama (Llama)
| 產品貨號 | 產品名稱 | 來源 |
|---|---|---|
| CSB-YP774725LBS CSB-EP774725LBS CSB-BP774725LBS CSB-MP774725LBS CSB-EP774725LBS-B |
Recombinant Lama glama Interleukin-1 alpha (IL1A) | Yeast E.coli Baculovirus Mammalian cell In Vivo Biotinylation in E.coli |
IL1A ELISA Kit
IL1A ELISA Kit for Bos taurus (Bovine)
| 產品貨號 | 產品名稱 | 樣本類型 | 靈敏度 |
|---|---|---|---|
| CSB-E12019B | Bovine Interleukin 1,IL-1 ELISA Kit | serum, plasma, tissue homogenates | 250 pg/mL |
IL1A ELISA Kit for Oryctolagus cuniculus (Rabbit)
| 產品貨號 | 產品名稱 | 樣本類型 | 靈敏度 |
|---|---|---|---|
| CSB-E06896Rb | Rabbit Interleukin 1,IL-1 ELISA Kit | serum, plasma, tissue homogenates | 3.9 pg/mL |
IL1A ELISA Kit for Homo sapiens (Human)
| 產品貨號 | 產品名稱 | 樣本類型 | 靈敏度 |
|---|---|---|---|
| CSB-E04620h | Human Interleukin 1α,IL-1α ELISA Kit | serum, plasma, tissue homogenates, cell lysates, cell culture supernates. | 0.975 pg/ml. |
IL1A ELISA Kit for Mus musculus (Mouse)
| 產品貨號 | 產品名稱 | 樣本類型 | 靈敏度 |
|---|---|---|---|
| CSB-E04621m | Mouse Interleukin 1α,IL-1α ELISA kit | serum, plasma, tissue homogenates | 0.58 pg/ml |
IL1A ELISA Kit for Sus scrofa (Pig)
| 產品貨號 | 產品名稱 | 樣本類型 | 靈敏度 |
|---|---|---|---|
| CSB-E09725p | Pig Interleukin 1α,IL-1α ELISA kit | serum, plasma, cell culture supernates, tissue homogenates | 6.25 pg/mL |
IL1A ELISA Kit for Rattus norvegicus (Rat)
| 產品貨號 | 產品名稱 | 樣本類型 | 靈敏度 |
|---|---|---|---|
| CSB-E04622r | Rat Interleukin 1α,IL-1α ELISA kit | serum, plasma, tissue homogenates. | 19.5 pg/ml. |
IL1A ELISA Kit for Monkey
| 產品貨號 | 產品名稱 | 樣本類型 | 靈敏度 |
|---|---|---|---|
| CSB-E10041Mo | Monkey Interleukin-1 alpha (IL1A) ELISA kit | serum, plasma, tissue homogenates | 1.95 pg/mL |











